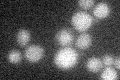
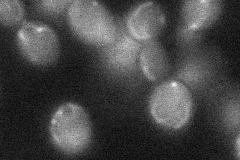

View description
Alkaline ceramidase that also has reverse (CoA-independent) ceramide synthase activity, catalyzes both breakdown and synthesis of phytoceramide; overexpression confers fumonisin B1 resistance
Localization:
Intensity:
Fold change:
Significance:
-
C’ GFP library in SD
below threshold14.1 -
N' NOP1pr-GFP in SD

ER35.3916 -
N' TEF2pr-mCherry in SD

ER11.7372 -
N' NATIVEpr-GFP in SD

below threshold19.9411 -
N' TEF2pr-VC and Cyto-VN in SD
below threshold27.6952 -
C’ GFP library in SD+DTT

cytosol13.170.93No -
C’ GFP library in SD+H2O2

cytosol15.161.07No -
C’ GFP library in Starvation Media

cytosol14.571.03No -
C’ GFP library on the background of Pup2-DaMP

below threshold -
C’ GFP library on the background of CCT mutant

below threshold16.27781.15407No
